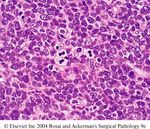
Hodgkin's Lymphoma Dr. Geetika Vohra Department of Pathology

Hodgkin's Lymphoma Dr. Geetika Vohra Department of Pathology
←
→
Page content transcription
If your browser does not render page correctly, please read the page content below
LYMPH NODE Imp component of lympho reticular system Others- thymus spleen tonsils inc adenoids Peyer s patches Less organised –Bone Marrow MALT-lungs , GIT
Structure of LN
Capsule-perforated by afferent lymphatic
channels
Enter into sub capsular sinus
Branch
Terminate at concavity or hilum as efferent
lymphatic vesselLymphoid folls B cell areas Ag.ic stim –dev G. C. Composed of FCC Surr by small LCs(mantle zone) Outside mantle zone –marginal zone.
Causes of LN opathy Non neoplastic & neoplastic Non Neo-Inflammatory Immune response Neoplastic –primary Secondary(Metastatic deposits) Primary Lymphoma Plasma cell disorders Langerhans cell histiocytosis
Introduction
Lymphomas are malignant tumours of lymphoreticular origin i.e.,
lymphocytes, histiocytes and their precursor cells.
Usually lymphoma begins in and involves L. nodes predominantly,
although other sites such as spleen, GIT, are frequent areas of
origin as well.
In advanced stage, infiltration of neoplastic cells are found in many
organs throughout the body and several forms of lymphomas (SLL,
lymphoblastic lymphoma, and Burkitt’s lymphoma) have leukemic
stages as part of their natural progression.
Clinically and pathologically lymphomas are quite heterogeneous.
However, two distinct clinico-pathologic groups are routinely
distinguished: Hodgkin’s lymphomas (HL) and non-Hodgkin’s
lymphomas (NHL).Clinical Differences between HL &
NHL
HL NHL
More often localized to single axial group of More frequent involvement of multiple
nodes peripheral node
Orderly spread by contiguity Non-contiguous spread
Extranodal involvement uncommon Extranodal involvement common
Rare involvement of mesenteric node, Common involvement of mesenteric
Waldeyer ring node, Waldeyer ringEpidemiology of lymphomas
5th most frequently diagnosed cancer in both sexes
Males > females
Incidence
NHL increasing
Hodgkin lymphoma stableRelative frequencies of different lymphomas
Non-Hodgkin Lymphomas
Diffuse large B-cell
Hodgkin
NHL Follicular
lymphoma
Other NHL
~85% of NHL are B-lineageHodgkin’s Lymphoma
Originally described by Thomas Hodgkin in 1832
Malignant lymphoma in which Reed Sternberg (R.S.)
cells are present in a characteristic background of reactive
inflammatory cells of various types accompanied by
fibrosis of various degree.
HL accounts for about 20-30% of lymphoma
Overall Male>Female
Incidence:
Bimodal peaks- one in young adult and second in
5th decadeEtiopathogenesis of HL
EBV- has been implicated in pathogenesis in HL on basis of
epidemiological, serological studies. Recently, molecular studies
revealed genome of EBV in R.S. cells in most of the cases.
Genetic etiology- HL is about 99 times more common in identical
twin of affected case compared to general population.
Cytokines- Presence of reactive inflammatory cells in HL is due to
secretion of cytokines from R.S. cellsHodgkin’s Lymphoma
Gross Features:
L. nodes are enlarged, soft to
hard depending on the
amount of fibrosis, foci of
necrosis is present. In
advanced stage several L.
nodes from same group
become matted together.
HL(gross): Note nodularity and
sclerosis.Hodgkin’s Lymphoma
M/E: R.S. cells are large (20-50µm)
abundant weakly acidophilic cytoplasm witch
may appear homogenous or granular
nucleus-bilobed or polylobed, so that cell
appear binucleated or multinucleated,
nuclear membrane is thick and sharply
defined. Nuclear pattern is vesicular,
nucleolus is large rounded highly acidophillic
centrally located surrounded by clear halo. In
R.S. cells 2 nuclear lobes face each other
(mirror image) gives ‘owl eye’
appearance, when nuclear lobation is
lacking cells are k.a. mononuclear variants
of R.S. cells/ Hodgkin’s cells.RS cell Lacunar variant
Mummified variant Immunophenotype of HRS cells Positive markers - CD30 & CD15 (75-85%)- Membranous with accentuation in the Golgi region - PAX5- 95%, weaker than reactive B-cells - IRF/MUM1 - CD20- 30-40% - CD79a- Less often expressed - EBV infected cells- LMP1 and EBNA1 Negative markers- EMA, OCT-2, BOB.1
R.S. cells of HL needs to be differentiated from other
mononucleated cells that may be present in L. nodes
such as
1. Megakaryocytes- but they are strongly PAS +ve, positivity for
factor VIII.
2. Pleomorphic immunoblasts seen in infectious mononucleosis,
having basophillic nucleolus, irregular contour, seen in adjacent
to nuclear membrane. Paranuclear hof- prominent , cytoplasm –
amphophilic, surrounded mononuclear immunoblasts,
plasmacytoid cells.
3. Neoplastic cells from a variety of epithelial as well as
mesenchymal tumour may resemble. E.g., Multiple myeloma,
osteoblastoma,of bone, malignant lymphoma of NHL type may
have cells like R.S. cells.
So it is important to examine not only R.S. cells but also
the background in which they are situated. The more
cytologically atypical the lymphoid population less likely
the diagnosis of Hodgkin’s Lymphoma.Reed–Sternberg-like cells in malignant melanoma (A), and osteoblastoma (B) A B
Jackson- Lukes-Butler Rye REAL WHO
Parker (1966) (1966) (1994) classificatio
(1944)
n (2008)
Paragranulo Lymphocytic &/or Lymphocyte Nodular Nodular
ma histiocytic predominance lymphocyte lymphocyte
-Nodular predominance predominance
-diffuse
Classical HL Lymphocyte C
rich L
Granuloma Nodular sclerosis Nodular Nodular Nodular A
sclerosis sclerosis sclerosis S
S
Mixed cellularity Mixed Mixed cellularity Mixed I
cellularity cellularity C
A
Sarcoma Diffuse fibrosis Lymphocyte Lymphocyte Lymphocyte L
depleted depleted depleted
ReticularNodular Lymphocytic Predominance HL
The predominant cell is small B lymphocyte with or without an accompanying
population of benign appearing histiocytes.
L. node architecture is partially or totally effaced and infiltrate has a nodular
pattern of growth,
Nodularity is so pronounced as to simulate on low power the apperance of
follicular lymphoma, but nodules of this disease are more irregular in size and
staining quality with admixture of lymphocyte epitheloid cells gives them a
mottled appearance, eosinophils, plasma cells, foci of fibrosis are scanty or
absent.
There is a large number of type of R.S.cell k.a. ‘Popcorn’ cells-characterized
by folded multilobed nucleus with smaller nucleoli. If numerous typical R.S. cells
are found in lymphocyte predominant background, then case probably belongs
to lymphocyte-rich type.
There is convincing evidence that the lymphoma has origin from germinal centre
cell at the cetroblastic stage of differentiation.Lymphocyte predominant Hodgkin Lymphoma
Immunophenotype of LP cells Positive markers: - CD20, CD79a, CD75 ,BCL6, CD45 - EMA- 50% - OCT-2, BOB.1, Activation induced deaminase - Ig light and/or heavy chain- strong - IgD-9-27%, more common in young males - Ki-67 nuclear positivity Lack CD15 and CD30
Lymphocyte predominance Hodgkin’s lymphoma. Showing the lymphocytic and/or histiocytic (L&H) type of cell (“popcorn” cell) that is characteristic of this condition.
Nodular Sclerosis HL
Characterized in its fully developed stage by broad collagen bands
separating the lymphoid tissue in well defined nodules.
In addition to the classic R.S. cells, the lymphoma displays a variant of
R.S. cell k.a. lacunar cells. This is quite large (40-50µm) with an
abundant clear cytoplasm and multilobulated nuclei having complicated
infoldings and nucleoli are smaller in size than those of classic R.S.
cells.
In some cases there is clustering of these lacunar cells around
necrosis, they form sheets and cohesive nests to the point that a
mistaken ∆is of large cell NHL, carcinoma, germ cell tumour, thymoma
can be made. This type of nodular sclerosis is k.a. sarcomatous/
syncytial variants.A well-developed case of nodular sclerosis Hodgkin’s lymphoma. The lymphoid nodule is encased in dense fibrohyaline tissue
Various appearances of lacunar cells in nodular sclerosis HL
Cellular phase of nodular sclerosis HL. Lacunar cells are plentiful
Mixed Cellularity HL Have large number of eosinophils, plasma cells, atypical mononuclear cells admixed with classic R.S. cells, which tend to numerous, necrosis is present but fibrosis is normal.
Mixed cellularity HL. Several diagnostic Reed–Sternberg cells are seen admixed with a polymorphic lymphoid infiltrate rich in eosinophil
Lymphocyte-Rich HL There is presence of R.S. cells scattered against a nodular or diffuse background largely composed of small lymphocytes and practically devoid of eosinophils and neutrophils. The main D/D is with NLPHD which shows popcorn cells where as it shows R.S. cells.
Lymphocyte-Depletion HL
Which comprises less than 5%; have 2 morphologic subtypes
Diffuse fibrosis: there is heavy deposition of collagen fibers,
number of lymphocytes and other cells are varying in
number.
Reticular subtype: is characterized by large number of
diagnostic R.S. cells among atypical mononuclear cells,
areas of necrosis is common.
It should be remembered that patient with HL may develop
in to NHL or leukemia either spontaneously or as a result of
therapy.Lymphocyte depletion type of HL. Numerous atypical cells are present in a densely fibrotic stroma. Lymphocytes are scanty
Biology of HRS
HRS cell origin: B-cell at the germinal centre stage
Lymphoma cells undergo reprogramming of gene expression
Loses the typical B cell surface and functional phenotype
Retain B-cell features associated with antigen presenting functions
and interaction with Th cells
Display an abnormal repertoire of membrane markers &
transcriptional regulator of multiple lympho-haematopoietic cell
typesMicroenvironment Cellular components Non-neoplastic B and T small lymphocytes Plasma cells Neutrophils Eosinophils Mast cells Histiocytes/ reticulum cells Fibroblasts Non cellular components Extracellular matrix components - fibronectin, tenascin Neo-angiogenesis
Hodgkin lymphoma microenvironment
Microenvironment formation
HRS cells are regulated by interactions among tumor cells and
reactive cells
Essential for :
Tumor cell growth and survival
To evade the host immune response
Non-malignant cells are recruited and/or induced to proliferate by
tumor cells
Cytokines & chemokines
Receptors in HRS cells TH2 cells and TReg cells: CCL5 (RANTES), CCL17, CCL22, CCL20 Eosinophils: IL-5, CCL5, CCL28, eotaxin and GM- CSF Mast cells: CCL5 Neutrophils : IL-8 Fibroblast : TNF α, IL-13, TGF β and b FGF Plasma cells: CCL28 Macrophages : GM-CSF EBV infection: IL-10, CCL5, CCL20 and CXCL10
Microenvironment formation
Microenvironment molecules as prognostic markers Adverse outcome IL-10 IL-6 CD30 TARC/CCL17 BAFF- resistance to therapy Soluble IL-7- advanced stages & presence of B symptoms
Non-Hodgkin Lymphoma (NHL)
A heterogeneous group of B- and T-cell malignancies that are
diverse in cellular origin, morphology, cytogenetic
abnormalities, response to treatment, and prognosis
Non-Hodgkin’s Lymphoma (NHL)
75% of lymphomas
6th major cause of cancer deaths yearly
Origin
principally B-cells derivation (>85%)
T-cells derivation
Histiocytes (very rarely)
Predominates in the 40-70 years age group
Slight male predominance overall Precursor B cell - Naïve B cells - Mantle cell - Centroblasts - Centrocytes -
Marginal zone cells Plasma cells
REAL/WHO Classification of NHL
B-CELL LYMPHOMAS (>85%)
Precursor B-cell neoplasms
Precursor B lymphoblastic leukemia/lymphoma
Mature B-cell neoplasms
Diffuse Large B-Cell Lymphomas (31%)
Follicular Lymphoma (22%)
Mucosa-Associated Lymphatic Tissue (MALT) Lymphoma (7.5%)
Small Lymphocytic Lymphoma-Chronic Lymphocytic Leukemia (7%)
Mantle Cell Lymphoma (6%)
Mediastinal (Thymic) Large B-Cell Lymphoma (2.4%)
Burkitt Lymphoma-Burkitt Leukemia (2.5%)
Lymphoplasmacytic Lymphoma-Waldenstrom Macroglobulinemia
(REAL/WHO Classification of NHL
Mature B-cell neoplasms (contd)
Plasma cell myeloma
Solitary plasmacytoma of bone
Extraosseous plasmacytoma
Extranodal Marginal Zone B-Cell Lymphoma (REAL/WHO Classification of NHL
T-CELL and NK CELL NEOPLASMS
Precursor T-cell neoplasms
Precursor T lymphoblastic leukemia/lymphoma
Blastic NK cell Lymphoma
Mature T and NK Cell Lymphomas (~12%)
Extranodal T or NK-Lymphoma
Cutaneous T-Cell Lymphoma (Sézary Syndrome and Mycosis
Fungoides)
Anaplastic Large Cell Lymphoma
Angioimmunoblastic T-Cell Lymphoma
T-cell prolymocytic Lymphoma
T-cell large granular lymphocytic leukemia
Adult T-cell leukemia/Lymphoma
Enteropathy-type T-cell Lymphoma
Hepatosplenic T-cell Lymphoma
Subcuataneous panniculitis-like T-cell Lymphoma
Primary Cutaneous anaplastic large cell lymphoma
Peripheral T-cell Lymphoma, UnspecifiedPrecursor B & T lymphoblastic
leukemia/lymphoma
B-ALL peaks in incidence at about the age of
3, perhaps because the number of normal
bone marrow pre-B cells (the cell of origin) is
greatest very early in life.
the peak incidence of T-ALL is in
adolescence, the age when the thymus
reaches its maximal size.
B- and T-ALL also occur less frequently in
adults In leukemic presentations, the marrow is
hypercellular and packed with lymphoblasts,
which replace the normal marrow elements.
Mediastinal thymic masses occur in 50% to
70% of T-ALLs, which are also more likely to
be associated with lymphadenopathy and
splenomegaly.CLINICAL FEATURES
Abrupt stormy onset within days to a few
weeks of the first symptoms •
Symptoms related to depression of
marrow function, including fatigue due to
anemia; fever, reflecting infections secondary
to neutropenia; and bleeding due to
thrombocytopenia Mass effects caused by neoplastic infiltration
(which are more common in ALL), including bone
pain resulting from marrow expansion and infiltration
of the subperiosteum; generalized
lymphadenopathy, splenomegaly, and
hepatomegaly; testicular enlargement; and in T-ALL,
complications related to compression of large
vessels and airways in the mediastinum •
Central nervous system manifestations such as
headache, vomiting, and nerve palsies resulting
from meningeal spread, all of which are also more
common in ALLMORPHOLOGY
In both B- and T-ALL, the tumor cells have
scant basophilic cytoplasm and nuclei
somewhat larger than those of small
lymphocytes
The nuclear chromatin is delicate and finely
stippled, and nucleoli are either absent or
inconspicuous.Lymphoblastic lymphoma. In this example the nuclear convolutions are barely evident
the mitotic rate is high. As with other rapidly
growing lymphoid tumors, interspersed
macrophages ingesting apoptotic tumor cells
may impart a “starry sky” appearance lymphoblasts are myeloperoxidase-negative
and often contain periodic acid–Schiff-
positive cytoplasmic material. Immunophenotype.
Immunostaining for terminal
deoxynucleotidyl-transferase (TdT), a
specialized DNA polymerase that is
expressed only in pre-B and pre-T
lymphoblasts, is positive in more than 95% of
casesSmall Lymphocytic Lymphoma (SLL)/
Chronic Lymphocytic Leukemia (CLL)
These two disorders are morphologically,
phenotypically and genetypically
indistinguishable, differing only in the degree
of peripheral blood lymphocytosis.
Most patients have sufficient lymphocytosis
to fulfill the diagnostic requirement of CLL
(absolute lymphocyte count >5000/cumm)
which is the most common leukemia of
adults.
In contrast, SLL constitutes only 4% of NHL C/F-Age: >50 years, M>F,
Patients are often asymptomatic, when symptoms present
they are non-specific, generalized LAP, hepatosplenomegaly
are seen (50-60%).
pts with CLL usually have WBC count >2,00,000/cumm
Hypogammaglobinemia is common- ↑ed infection
10-15%pts P/C Autoimmune hemolytic anemia or
thrombocytopenia
Prognosis-variable, median survival is 4-6 years Morphology-
L. node architecture is diffusely effaced by a predominant
population of S. lymphocytes (6-12µm) containing round to
slightly irregular nuclei with condensed chromatin and
scant cytoplasm.
In addition some time these cells are mixed with variable
number of large cells called prolymphocytes (vesicular
nuclei with prominent nucleoli). These prolymphocytes, if
form loose aggregates focally referred to as proliferation
centres, they contain cells showing high mitotic activity.
In CLL- Peripheral blood contains increased number
of small lymphocytes these cells are fragile, gets
disrupted form smudge cells. All cases of CLL
show involvement of BM and most of the cases of
SLLLow-power view of small lymphocytic lymphoma. A monotonous proliferation of small lymphocytes effaces the architecture of the node.
High-power view of small lymphocytic lymphoma. The nuclear contours are regular, the chromatin is clumped, and nucleoli are inconspicuous
So-called “growth center” in a lymph node involved by SLL
Transformation (of SLL/CLL) to other aggressive lymphoma Prolymphocytic transformation_ (15-30%) cases- there is worsening of cytopenia, ↑ing splenomegaly, peripheral blood shows ↑ed number prolymphocytes Richter syndrome-(10%) cases- there is transformation in to diffuse large B cell lymphoma- there is appearance of a rapidly enlarging mass with in L. node and spleen and patients’ survival becomes less than 1year Sometime SLL present with R.S. cells suggesting a possibility of transformation to HL
Immuno-phenotype: express pan B-cell
markers CD19, CD20, in addition –CD23,
CD5.
Cytogenetics and molecular genetics-
chromosomal translocations are rare.
Most common findings are deletions of
13q12-14, deletion of 11q, trisomy 12q, and
deletions of 17p. DNA sequencing
suggests that cell of origin may be a
postgerminal centre memory B-cell or
naïve B-cell.Various morphologic types of lymph node involvement by CLL. A, monotonous infiltrate of small mature lymphocyte B. Somewhat immature forms with slightly large nuclei & more open chromatin. C. large pleomorphic cell (Richter’s syndrome) A B C
Follicular Lymphoma
It is B-cell neoplasm that recapitulates the architectural and cytologic features of the normal
secondary lymphoid follicles
40% of all NHL, occur in elderly, unusual under 20 yrs of age
Grossly and lower power- shows nodular pattern of growth with progression –nodularity
becomes blurred and eventually most of the proliferation shows a diffuse pattern
Cytologically: shows mixture of different proportion of small and large lymphoid cells which
resemble their normal follicular counterparts. The small cells have scanty cytoplasm and an
irregular, elongated cleaved nucleus with prominent indentation and infoldings; the size is
similar or slightly larger than that of normal lymphocytes, chromatin- coarse, nucleolus-
inconspicuous. These cells are called centrocytes, or small cleaved follicular center cells
Larger cells are 2-3 times the size of normal lymphocytes they have a distinct rim of
cytoplasm, vesicular nucleus with one or three nucleoli often adjacent to the nuclear
membrane, these cells represent the proliferating component of the tumour k.a.
centroblasts, large (cleaved/non-cleaved) follicular central cells.
Other large cell seen in follicular lymphoma is non-neoplastic dentritic follicular cells having
finely dispersed chromatin, lack of identifiabl;e cell boundaries and the inconspicuous of
the nucleolus.Follicular Lymphoma
Immunohistochemically- follicular lymphomas composed of monoclonal population of B
cells admixed with non-neoplastic population of all the elements of normally present in a
normal germinal center including follicular centre B cell, small T-cell, mac, and follicular
dendritic cells. Tumour cells express pan B antigens CD19, CD20, CD12, CD74; also
expresses surface or cytoplasmic Ig. CD5 and CD43 are usually negative.
CD10-(CALLA) has been detected in 60-70% of cases, it is also used for D/D with follicular
hyperplasia(-ve) and it is an indicator of follicle center origin if present in a diffuse large cell
lymphoma.
Cytogenetically-85% of cases have t(14;18) translocation . This results in the bcl-2 gene
being translocated from its normal position on Ch.18 to Ch. 14.bcl-2 gene is an integral
membrane protein located in inner mitochondrial membrane which functions as a
suppressor of apoptosis. It is identified by Southern blot, PCR & immunochemistry, present
in approximately 85% of follicular lymphoma and absent in follicular hyperplasia.
Other translocation-t(8;14),rearrangement of bcl-6 located in chromosome 3q27
Categories-depending upon –relative proportion of small and large cells. It is divided in to 3
categories
1. Predominantly small cleaved cells, large cells areEven distribution of neoplastic follicles in follicular lymphoma (B), as opposed to the predominantly cortical distribution typical of follicular hyperplasia (A). A B
Follicular Lymphoma
Variations-morphological
Presence of fine or coarse bands of fibrosis that gives a nodular character of the lesion
and may get confused with carcinoma
Presence of monocytoid B cells , seen in 10% of cases . Molecular studies have shown
a common clonal origin of these cells from follicle center cells.
Deposition of proteineceous material in the centre of the nodules
Presence of large cytoplasmic eosinophilic globules that push the nucleus laterally and
results a signet ring effect.
Plasmocytic differentiation in some or many of cells.
Permeation of the tumour follicle by small round lymphocytes of mantle zone region,
the appearance simulating that of progressively transformed germinal centre (floral
variant).
Presence of rosettes made up of cytoplasm and cytoplasmic processes of the
lymphoid tumour cells.
Inversion of the usual staining pattern as seen in low power, the neoplastic follicles
appear darker than the surrounding lymphoid tissue . This pattern which is referred to
as reverse or inverse variant of follicular lymphoma, have no prognostic significance.
Prominent epitheloid grannulomateous responseFollicular Lymphoma
C/F: painless generalized LAP, involvement of extranodal site such as-
such as GIT, CNS, testis- relatively uncommon- it is incurable but
follows indolent waxing and waning course.
Median survival is 7-9year and is not improved by aggressive therapy.
So T/T approach is low dose chemotherapy/radiotherapy, when pt
becomes symptomatic
Histologic transformation occurs in 30-50% of cases most commonly to
diffuse large b-cell lymphoma. Rarely it transform to an aggressive
tumour resembling Burkitt’s lymphoma. Median survival is less than I
year after transformation
P/blood- involvement produce lymphocytosis is seen in 10% of cases
BM- 85% of cases
Splenic and hepatic involvement is also frequently seen.Homogeneous population of small cleaved cells in follicular lymphoma (B), as opposed to the polymorphic composition seen in follicular hyperplasia, including the presence of tingible-body macrophages (A). follicular lymphoma A B
Marked contrast between the cleaved cells of follicular lymphoma (B) and the regular mature lymphocytes of small lymphocytic lymphoma (A) A B
Malignant lymphoma featuring signet ring changes in some of the tumor cells.
Follicular lymphoma with deposition of proteinaceous material among the tumor cells. Ultrastructurally, some of this material was found to be within the cytoplasm of dendritic follicular cells.
Mantle Cell Lymphoma
Low grade lymphoma, it comprises 3-10% of all NHL
Occurs in 5th-6th decade of life, shows male predominance
The tumour cells closely resemble the normal mantle zone B-cells that
surround the geminal centres
Morphology- Tumours cells may be surround reactive/or residual
germinal centres, producing a vaguely nodular appearance at low
power or diffusely effaced nodal architecture. Typically population
consists of a hemogenous population of small lymphocytes with round
to irregular to occasionally deeply clefted nuclear contours.
So most of the small lymphocytes are similar to those of SLL and other
showing slightly irregular and indented nuclear contours resemble to
small cleaved cells follicular lymphoma
In some cases, tumour cells have large nuclei with more dispersed
chromatin and higher proliferative factor k.a. blastic variant which is
associated with BM and spleen involvement.Mantle Cell Lymphoma
Two commonly seen morphologic features of this lymphoma are
Hyalinized blood vesels
Scattering of epithelioid histiocytes resulting in a starry sky appearance
Immunocytochemistry studies show that this is a distinct type of lymphoma having a
features of lymphocytes of primary follicle or mantle zones of secondary follicles.
Tumours cells are positive for Ig (IgM, IgD) B-cell associated antigen and CD5.
Absence of CD23- is useful for distinguishing it from SLL and presence of CD5 is useful in
D/D with follicular and marginal zone lymphoma.
Cytogenetically-t(11;14), translocation is present 70% of cases which is detected by FISH.
This translocation leads to overexpression of cyclin D1 protein which is constant and very
specific feature of this lymphoma.
This cyclin D1 protein promotes G1 to S phase progression during cell cycle
This lymphoma may be difficult to distinguish from mantle zone hyperplasia and
Castkleman’s disaes. Determination of clonality of the infiltrate by ICC technique is
important in this regard.
In D/D with follicular lymphopma, clue is absence of centroblasts and immunoblasts in this
lymphoma
Blastic form of this lymphoma needs to be distinguished from lymphoblastic lymphoma.
C/F: Painless LAD, with splenomegaly (50%). Prognosis- poor, median survival- 3-4 years.Mantle cell lymphoma surrounding a small residual germinal center.
y p and that of small lymphocytic lymphoma.
So-called “blastoid variant” of mantle cell lymphoma. A, section showing high mitotic activity.
Marginal Zone B-cell Lymphoma
In this lymphoma, predominant tumour cell resemble normal marginal
zone B-cells which represents a post germinal centre memory B-cell
population.
Marginal Zone B-cell Lymphoma is the generic term used to designate
a large family of low grade B-cell lymphoma such as
1. Monocytoid B-cell Lymphoma (L.node). Tumour cells are small to medium
sized lymphocytes with round or slightly indented nuclei and relatively
abundant clear, cytoplasm.
The pattern of involvement is predominantly sinusal and
interfollicular, nodal form of this lymphoma is very rare
disease (Marginal Zone B-cell Lymphoma
2. Low grade lymphoma of Mucosa associated Lymphoid Tissue (MALT-Lymphoma)-
in this lymphoma, cell population includes – small round lymphocytes, monocytoid B-
cells, cells with slightly irregular nuclei (centrocyte like) plasmacytoid cells, plasma cells
and occasional large lymphoid cells.
Tumour is seen exranodal sites in realation to mucosa or glandular epithelia, such
as GIT, salivary, lacrimal gland, lung, thyroid, bladder skin, it remains localised for
long time and has tendency to relapse in the same site or other extranodal sites.
They often arise with in tissue involved by chronic inflammatory disorders of
autoimmune or infectious etiology e.g., tumours arising from salivary gland in
Sjogren disease, thyroid gland in Hashimoto thyroiditis and the stomach in
Helicobacter gastritis, these tumour may regress if inciting agent is eradicated.
Immunohistochemically-there is no special cell marker that separate MALT
lymphoma from others low grade B-cell lymphoma, however, as a group they are
less likely to express CD5, CD25, and more likely to express CD11c. Trisomy 3 is
frequent and some cases show t(11;18).
3. Splenic Marginal Zone Lymphoma- several cases of lymphoma involving the marginal
zone of the spleen have been reported, some time is association with BM and
peripheral blood involvement.
Transformation to large cell lymphoma can occur in any forms of marginal zone B-cell
lymphomaLymph node involvement by marginal zone B-cell lymphoma. There are numerous residual germinal centers.
Diffuse Large B cell Lymphoma
Most complex, heterogeneous of all NHL. This term replaces the old
histiocytic lymphoma. It constitutes about 20% of all NHL and 60-70%
of aggressive lymphoid neoplasms.
Median age is about 60 years. However age range is wide and it also
constitutes about 5% of childhood lymphoma.
Morphologically- characterized by the large size of the cells, their
vesicular nuclei, with prominent nucleoli with abundant cytoplasm.Gross appearance of lymph nodes involved by non-Hodgkin’s lymphoma of diffuse large B-cell type. The nodes are enlarged and show a homogeneous tan cut surface.
Diffuse Large B cell Lymphoma
40% cases shows extranodal sites; GIT, skin, skeletal system, liver,
spleen. The involve nodes are usually markedly enlarged, homogenous
with little or no necrosis. BM involvement usually occurs late. Rarely
leukemic picture may emerge
Progression- rapid, prognosis-poor if untreated, but shows excellent
response to chemotherapy
50-60% of large cell lymphoma has B-cell marker
5-15% has T-cell marker.
A few have true histiocytic features
And if no marker at all k.a. Null Lymphoma
Microscopically- pattern – diffuse, mitosis- are numerousDiffuse Large B cell Lymphoma
Subclassification depending upon type of large cell present
Centroblastic- it is a diffuse counterpart of the nodular form of follicular
lymphoma.
Composed of an admixture of varying proportion of cleaved and non cleaved
large cells. When non cleaved cells predominate, distinction with immunoblastic
variant becomes difficult.
The main morphologic difference are –lighter staining, less pyroninophilic
cytoplasm, the more peripheral location of the nucleoli, absence of plasmocytoid
differentiation, presence of scattered small and large cleaved cells.
Immunoblastic- tumour cells have appearance of an immunoblast, large
vesicular nucleus with prominent central nucleolus and thick nuclear membrane
and deeply amphophilic and pyroninophilic; cytoplasm with a distinct nuclear hof,
some of the cells are binucleated, multinucleated and may resemble R.S. cell and
other acquire plasmocytoid appearance.
This type of lymphoma is associated or arising on the basis of mutual
immunodeficiency, Immunosuppression and immunoproliferative statesHigh-power views of diffuse large B-cell lymphoma of large cleaved type.
High-power views of diffuse large B-cell lymphoma of immunoblastic type.
Marked sclerosis and hyalinization in diffuse large B-cell lymphoma.
Burkitt’s Lymphoma
High grade malignant lymphoma composed of germinal centre B cell which
can present in 3 clinical settings.
Endemic-occurs in Aferica, most common form of childhood malignancy
in this area. Pts. Present with jaw and orbital lesions.
Sporadic- affects mainly children and adolescents seen through out the
world, greater tendency for involvement of the abdominal cavity.
Immunodeficiency associated: seen in cases with HIV infection.
In all three forms peripheral lymphoadenopathy is rare. Bone marrow
involvement is common in later stage.
M/E- seen in diffuse form, however, earlier stage shows involvement of
germinal centres. Tumour cells are small (10-25µm) & round; nuclei- round,
oval, and have several basophilic prominent nucleoli, chromatin- coarse and
nuclear membrane is thick. Cytoplasm- it is amphophilic and strongly
pyroninophilic, mitosis are numerous and a prominent starry sky pattern.
E/M- there is abundant ribosomes, glycogen, particles and presence of
nuclear packets or projections.Burkitt’s lymphoma with characteristic starry sky appearance.
Burkitt’s Lymphoma
Morphological variants: two mainly
Plasmacytoid differentiation- common in HIV, basophilic cytoplasm
containing Ig and a single central nucleolus.
Atypical/pleomorphic form- cell size larger, distinct pleomorphism is
present, most of the cells have a well defined rim of cytoplasm nucleus
contain a large eosinophilic nucleolus, binucleated/multinucleated cells
are common. Phagocytosis of nuclear debris by reactive histiocytes is
common, resulting in a starry sky appearance.
Immunohistochemically – all cases of this lymphoma are B-cell lineage
Cytogenetically- 80% shows t(8;14) translocation, which results in the
juxtaposition of the myc gene, so there is deregulation of myc gene
expression, and ↑ed cell proliferationModified Ann Arbor Staging
Stage I Involvement of a single lymph node region
Stage II Involvement of ≥2 lymph node regions on the same side
of the diaphragm
Stage III Involvement of lymph node regions on both sides of the
diaphragm
Stage IV Multifocal involvement of ≥1 extralymphatic sites ±
associated lymph nodes or isolated extralymphatic organ
involvement with distant nodal involvementYou can also read